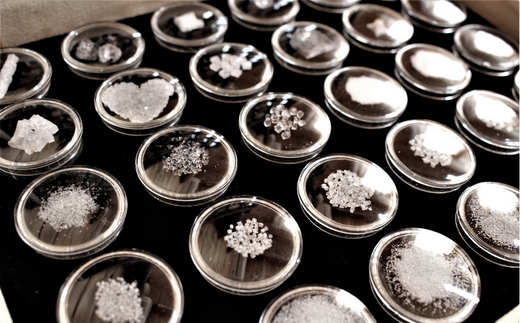
田野屋紫蘭の完全天日塩 清流安田川が育む土佐の海と太陽で育てた｢万能｣小粒100g×3個 田野屋紫蘭 塩 完全 天日塩 セット 万能 小粒 100g 3袋 しお 荒塩 あら塩 天然 料理 調味料 食塩 高知県 安田町 TN-03

-
- 常温
高知県 安田町
田野屋紫蘭の完全天日塩 清流安田川が育む土佐の海と太陽で育てた「万能」小粒100g×3個 田野屋紫蘭 塩 完全 天日塩 セット 万能 小粒 100g 3袋 しお 荒塩 あら塩 天然 料理 調味料 食塩 高知県 安田町 TN-03
- 0.0
- (0)
寄附金額 13,000円在庫あり- 決済方法
- 数量
-
返礼品の特徴
清流安田川が流れ込む土佐の海水を原料に、太陽光と塩職人・田野屋紫蘭の技で結晶化させた「完全天日塩」です。
・「万能」 小粒 100g
とても優しい味わいで、どんな素材や調理方法にも使いやすいミネラルバランス。
前職は、夫婦とも埼玉県の市役所に勤めていました。
師匠の塩に衝撃を受け、人生をかけて取り組むべき仕事だと感じ、退職し結婚して移住。
新婚生活が修行という特殊な環境の中、3年間1日も休まずに塩と向き合い、生活のすべてを塩漬けにして完全天日塩製法を習得することができました。
その修行で培ったノウハウとオリジナルの技術を組み入れ、品質を追求した結果「海水から塩の結晶化」まで、一貫して結晶ハウスの屋内で育てる手法をとっています。
夏場で3ヶ月、冬でも6ヶ月、夏場の結晶ハウスは70度にもなりますが、毎日休みなく海水を混ぜることでゆっくりと塩を結晶化させていきます。
膨大な時間と手間暇をかけるのは、ミネラルを「壊さず損なわず」塩の「味・形・大きさ」を調整し、人の体や素材、調理方法に合った塩を作りたいという思いからです。
「海と人の架け橋」となり「素材を際立たせる」塩を、ぜひお愉しみください。
【保存方法】高温多湿を避け、常温保存
北海道千歳市クーポン利用可能施設(一例)
| 千歳ステーションホテル | http://www.chitose-sh.com/ |
|---|---|
| ホテルウィングインターナショナル千歳 | http://www.hotelwing.co.jp |
| ホテルグランテラス千歳 | http://breezbay-group.com/hgt-chitose/ |
| 千歳エアポートホテル | http://www.airport-hotel.co.jp |
| しこつ湖鶴雅リゾートスパ水の謌 | http://www.mizunouta.com/ |
| 支笏湖第一寶亭留 翠山亭 | http://www.shikotsuko-daiichi.com/ |
| 湖畔の宿支笏湖 丸駒温泉旅館 | https://www.marukoma.co.jp/ |
| エアターミナルホテル | http://www.air-terminal-hotel.jp/ |
| ポルトムインターナショナル北海道 | https://www.portom.jp/jp/ |
| しこつ湖鶴雅別荘 碧の座(四季島) | https://www.aonoza.com/ |
その他の施設もございます。ご予約時に「検索結果画面」にてご確認ください。
満席・満室等の理由により「検索結果画面」にて施設および対象プランが表示されない場合があります。あらかじめご了承ください。
満席・満室等の理由により「検索結果画面」にて施設および対象プランが表示されない場合があります。あらかじめご了承ください。
愛知県名古屋市クーポン利用可能施設(一例)
| ホテルJALシティ名古屋 錦 | https://www.nagoya-nishiki.jalcity.co.jp/ |
|---|---|
| ニッコースタイル名古屋 | https://nagoya.nikkostyle.jp/ |
| コートヤード・バイ・マリオット名古屋 | https://www.marriott.com/ja/hotels/ngocy-courtyard-nagoya/overview/ |
| 名古屋東急ホテル | https://www.tokyuhotels.co.jp/nagoya-h/index.html |
| ダイワロイネットホテル名古屋駅前 | https://www.daiwaroynet.jp/nagoyaekimae/ |
| 名古屋栄ワシントンホテルプラザ | http://washington.jp/sakae |
| ダイワロイネットホテル名古屋新幹線口 | http://www.daiwaroynet.jp/nagoya-shinkansenguchi/ |
| ホテルリソル名古屋 | https://www.resol-hotel.jp/nagoya/ |
| ヒルトン名古屋 | https://www.hiltonnagoya.com/ |
| 三井ガーデンホテル名古屋プレミア | http://www.gardenhotels.co.jp/nagoya-premier/ |
その他の施設もございます。ご予約時に「検索結果画面」にてご確認ください。
満席・満室等の理由により「検索結果画面」にて施設および対象プランが表示されない場合があります。あらかじめご了承ください。
満席・満室等の理由により「検索結果画面」にて施設および対象プランが表示されない場合があります。あらかじめご了承ください。
北海道旭川市クーポン利用可能施設(一例)
| OMO7旭川 by 星野リゾート | https://omo-hotels.com/asahikawa/ |
|---|---|
| アートホテル旭川 | http://www.art-asahikawa.com/ |
| 天然温泉神威の湯 ドーミーイン旭川 | http://www.hotespa.net/hotels/asahikawa/ |
| 天然温泉プレミアホテル-CABIN-旭川 | https://cabin.kenhotels.com/asahikawa/ |
| コートホテル旭川 | http://www.courthotels.co.jp/asahikawa/ |
| ホテルクレッセント旭川 | http://www.hotel-cr.com/ |
| 旭川トーヨーホテル | http://toyo-hotel.net/ |
| JRイン旭川 | http://www.jr-inn.jp/asahikawa/ |
| ホテルウィングインターナショナル旭川駅前 | https://www.hotelwing.co.jp/asahikawa/ |
| ホテルアマネク旭川 | https://amanekhotels.jp/asahikawa/ |
その他の施設もございます。ご予約時に「検索結果画面」にてご確認ください。
満席・満室等の理由により「検索結果画面」にて施設および対象プランが表示されない場合があります。あらかじめご了承ください。
満席・満室等の理由により「検索結果画面」にて施設および対象プランが表示されない場合があります。あらかじめご了承ください。
神奈川県藤沢市クーポン利用可能施設(一例)
| ホテル法華クラブ湘南・藤沢 | https://www.hokke.co.jp/shonan-fujisawa/ |
|---|---|
| 相鉄フレッサイン藤沢湘南台 | https://sotetsu-hotels.com/fresa-inn/shonandai/ |
| 東横INN湘南鎌倉藤沢駅北口 | https://www.toyoko-inn.com/index.php/search/detail/00115/ |
| ホテルウィングインターナショナル湘南藤沢 | https://www.hotelwing.co.jp/shonan-fujisawa/ |
| スマイルホテル湘南藤沢 | https://smile-hotels.com/hotels/show/shonanfujisawa |
| キップホテル湘南藤沢 | https://kipphotel.com/ |
| アパホテル〈湘南 辻堂駅前〉 | https://www.apahotel.com/hotel/syutoken/kanagawa/shonan-tsujido-ekimae/ |
その他の施設もございます。ご予約時に「検索結果画面」にてご確認ください。
満席・満室等の理由により「検索結果画面」にて施設および対象プランが表示されない場合があります。あらかじめご了承ください。
満席・満室等の理由により「検索結果画面」にて施設および対象プランが表示されない場合があります。あらかじめご了承ください。
北海道網走市クーポン利用可能施設(一例)
| ホテルルートイン網走駅前 | https://www.route-inn.co.jp/hotel_list/hokkaido/index_hotel_id_502/ |
|---|---|
| 網走セントラルホテル | http://www.abashirich.com |
| 北天の丘 あばしり湖鶴雅リゾート | http://www.hokutennooka.com/ |
| ホテル網走湖荘 | https://www.abashirikoso.com/ |
| 網走ロイヤルホテル | http://abashiri-royal.jp/ |
| オーベルジュ北の暖暖 | http://kitanodandan.com |
| ホテル オホーツク・イン | https://www.ohotsuku-inn.co.jp/ |
| さんご草の郷 能取の荘 かがり屋 | http://www.kagariya.cc |
| ペンション わにの家 | https://waninoie.sakura.ne.jp |
| 天然温泉 天都の湯 ドーミーイン網走 | https://www.hotespa.net/hotels/abashiri/ |
その他の施設もございます。ご予約時に「検索結果画面」にてご確認ください。
満席・満室等の理由により「検索結果画面」にて施設および対象プランが表示されない場合があります。あらかじめご了承ください。
満席・満室等の理由により「検索結果画面」にて施設および対象プランが表示されない場合があります。あらかじめご了承ください。
沖縄県沖縄市クーポン利用可能施設(一例)
| オキナワグランメールリゾート | https://www.okinawa-grandmer.com/ |
|---|---|
| ホテルニューセンチュリー | http://www.hotelnewcentury.co.jp/ |
| クラウンホテル沖縄 | https://crownhotel.jp |
| デイゴホテル | http://www.deigo.jp |
| クラウンホテル沖縄アネックス | https://crownhotel.jp |
| ライカムファミリーリゾートホテル(旧ヒヤグンラナイリゾート) | https://www.hiyagun-lanairesort.jp/ |
| ホテルコザ | https://hotel-koza.jp/ |
| レフ沖縄アリーナbyベッセルホテルズ | https://www.vessel-hotel.jp/ref/okinawa/ |
その他の施設もございます。ご予約時に「検索結果画面」にてご確認ください。
満席・満室等の理由により「検索結果画面」にて施設および対象プランが表示されない場合があります。あらかじめご了承ください。
満席・満室等の理由により「検索結果画面」にて施設および対象プランが表示されない場合があります。あらかじめご了承ください。
奈良県奈良市クーポン利用可能施設(一例)
| ホテル日航奈良 | https://www.nikkonara.jp/ |
|---|---|
| コンフォートホテル奈良 | https://www.choice-hotels.jp/hotel/nara/ |
| ホテル尾花 | https://obana.nara.jp |
| 奈良ワシントンホテルプラザ | https://www.washingtonhotel.co.jp/whp/nara/ |
| 奈良パークホテル | https://www.narapark.jp/ |
| 春日ホテル | https://www.kasuga-hotel.co.jp/ |
| 天然温泉 吉野桜の湯 御宿野乃奈良 | https://dormy-hotels.com/dormyinn/hotels/nono_nara/ |
| JWマリオット・ホテル奈良 | https://www.marriott.com/ja/hotels/osajw-jw-marriott-hotel-nara/overview/ |
| ダイワロイネットホテル奈良 | https://www.daiwaroynet.jp/nara/ |
| ノボテル奈良 | https://www.novotelnara.com/ |
その他の施設もございます。ご予約時に「検索結果画面」にてご確認ください。
満席・満室等の理由により「検索結果画面」にて施設および対象プランが表示されない場合があります。あらかじめご了承ください。
満席・満室等の理由により「検索結果画面」にて施設および対象プランが表示されない場合があります。あらかじめご了承ください。
長崎県佐世保市クーポン利用可能施設(一例)
| ホテル日航ハウステンボス | http://www.nikko-htb.co.jp |
|---|---|
| 佐世保ワシントンホテル | http://www.sasebohotel.com |
| ホテルヨーロッパ ハウステンボス | https://www.huistenbosch.co.jp/hotels/he/ |
| ホテルリソル佐世保 | https://www.resol-hotel.jp/sasebo/ |
| フォレストヴィラ ハウステンボス | https://www.huistenbosch.co.jp/hotels/fv/ |
| ホテルアムステルダム ハウステンボス | https://www.huistenbosch.co.jp/hotels/am/index |
| 弓張の丘ホテル | http://www.yumihari.com/ |
| ホテルデンハーグ ハウステンボス | https://www.huistenbosch.co.jp/hotels/hd/ |
| ホテルオークラJRハウステンボス | https://www.jrhtb.hotelokura.co.jp |
| ホテルロッテルダム ハウステンボス | https://www.huistenbosch.co.jp/hotels/hr/ |
その他の施設もございます。ご予約時に「検索結果画面」にてご確認ください。
満席・満室等の理由により「検索結果画面」にて施設および対象プランが表示されない場合があります。あらかじめご了承ください。
満席・満室等の理由により「検索結果画面」にて施設および対象プランが表示されない場合があります。あらかじめご了承ください。
茨城県クーポン利用可能施設(一例)
| ホテル日航つくば | https://www.nikko-tsukuba.com/ |
|---|---|
| ホテルJALシティつくば | https://www.tsukuba.hoteljalcity.com/ |
| ダイワロイネットホテルつくば | http://www.daiwaroynet.jp/tsukuba/ |
| ダイワロイネットホテル水戸 | https://www.daiwaroynet.jp/mito/ |
| ホテルウィングインターナショナル日立 | http://www.hotelwing.co.jp/hitachi/ |
| JR東日本ホテルメッツ 水戸(旧ホテルメッツ水戸) | https://www.hotelmets.jp/mito/ |
| ホテルエリアワン東海 | https://www.hotel-areaone.com/tokai/ |
| ホテルエリアワン北茨城 | https://www.hotel-areaone.com/kitaibaraki/ |
| 天然温泉 香梅の湯 ドーミーイン水戸 | https://dormy-hotels.com/dormyinn/hotels/mito/ |
| ザ・セレクトン土浦駅前 | https://celecton.com/tsuchiura |
その他の施設もございます。ご予約時に「検索結果画面」にてご確認ください。
満席・満室等の理由により「検索結果画面」にて施設および対象プランが表示されない場合があります。あらかじめご了承ください。
満席・満室等の理由により「検索結果画面」にて施設および対象プランが表示されない場合があります。あらかじめご了承ください。
栃木県日光市クーポン利用可能施設(一例)
| ホテル ナチュラルガーデン日光 | https://www.n-garden-hotel.com/ |
|---|---|
| ホテルカジュアルユーロ | http://www.nikko-casual.jp |
| 鬼怒川 仁王尊プラザ | https://www.niousonplaza.com/ |
| 鬼怒川温泉 あさや | http://www.asaya-hotel.co.jp/ |
| 日光金谷ホテル | http://www.kanayahotel.co.jp/nkh/ |
| 日光きぬ川ホテル三日月 | https://www.mikazuki.co.jp/kinugawa/ |
| 鬼怒川プラザホテル | https://www.kinugawa.co.jp/plaza/ |
| 亀の井ホテル 奥日光湯元 | https://kamenoi-hotels.com/en/okunikko/ |
| 亀の井ホテル 日光湯西川 オールインクルーシブホテル | https://kamenoi-hotels.com/nikkoyunishigawa/ |
その他の施設もございます。ご予約時に「検索結果画面」にてご確認ください。
満席・満室等の理由により「検索結果画面」にて施設および対象プランが表示されない場合があります。あらかじめご了承ください。
満席・満室等の理由により「検索結果画面」にて施設および対象プランが表示されない場合があります。あらかじめご了承ください。
山形県山形市クーポン利用可能施設(一例)
| リッチモンドホテル山形駅前 | https://richmondhotel.jp/yamagata/ |
|---|---|
| ホテルメトロポリタン山形 | https://yamagata.metropolitan.jp/ |
| 山形駅西口ワシントンホテル | http://washington-hotels.jp/yamagata-ekinishiguchi/ |
| JURIN | https://zao-jurin.com/ |
| 名湯リゾート ルーセントタカミヤ | http://www.zao.co.jp/lucent/ |
| たかみや瑠璃倶楽リゾート | http://www.zao.co.jp/rurikura/ |
| ホテル喜らく | http://www.zao-kiraku.co.jp/ |
| 蔵王プラザホテル | http://www.zao-plaza.com/ |
| 名湯舎 創 | https://www.meitoya.com/ |
| ダイワロイネットホテル山形駅前 | https://www.daiwaroynet.jp/yamagata-ekimae/ |
その他の施設もございます。ご予約時に「検索結果画面」にてご確認ください。
満席・満室等の理由により「検索結果画面」にて施設および対象プランが表示されない場合があります。あらかじめご了承ください。
満席・満室等の理由により「検索結果画面」にて施設および対象プランが表示されない場合があります。あらかじめご了承ください。
沖縄県糸満市クーポン利用可能施設(一例)
| サザンビーチホテル&リゾート沖縄 | https://www.southernbeach-okinawa.com/ |
|---|---|
| 琉球ホテル&リゾート 名城ビーチ | https://ryukyuhotel.kenhotels.com/ |
その他の施設もございます。ご予約時に「検索結果画面」にてご確認ください。
満席・満室等の理由により「検索結果画面」にて施設および対象プランが表示されない場合があります。あらかじめご了承ください。
満席・満室等の理由により「検索結果画面」にて施設および対象プランが表示されない場合があります。あらかじめご了承ください。
宮城県仙台市クーポン利用可能施設(一例)
| ホテルJALシティ仙台 | http://www.sendai.jalcity.co.jp/ |
|---|---|
| ホテルモントレ仙台 | http://www.hotelmonterey.co.jp/sendai/ |
| 仙台国際ホテル | http://www.tobu-skh.co.jp/ |
| ダイワロイネットホテル仙台 | https://www.daiwaroynet.jp/sendai/ |
| ホテルメトロポリタン仙台 | https://sendai.metropolitan.jp/ |
| 三井ガーデンホテル仙台 | http://www.gardenhotels.co.jp/sendai/ |
| ウェスティンホテル仙台 | https://the-westin-sendai.com/ |
| 秋保グランドホテル | http://www.akiugrand.com/ |
| 茶寮 宗園 | https://saryo-souen.com/ |
| 仙台・秋保温泉 篝火の湯 緑水亭 | http://www.ryokusuitei.co.jp/ |
その他の施設もございます。ご予約時に「検索結果画面」にてご確認ください。
満席・満室等の理由により「検索結果画面」にて施設および対象プランが表示されない場合があります。あらかじめご了承ください。
満席・満室等の理由により「検索結果画面」にて施設および対象プランが表示されない場合があります。あらかじめご了承ください。
兵庫県神戸市クーポン利用可能施設(一例)
| 神戸メリケンパークオリエンタルホテル | http://www.kobe-orientalhotel.co.jp/ |
|---|---|
| ホテルオークラ神戸 | https://www.kobe.hotelokura.co.jp/ |
| 神戸ベイシェラトンホテル&タワーズ | http://www.sheraton-kobe.co.jp/ |
| ホテルモントレ神戸 | http://www.hotelmonterey.co.jp/kobe/ |
| 神戸ポートピアホテル | https://www.portopia.co.jp/ |
| ホテルパールシティ神戸 | https://hmihotelgroup.com/pearlcity-kobe/ |
| ORIENTAL HOTEL(オリエンタルホテル) | http://www.orientalhotel.jp/ |
| ホテルクラウンパレス神戸 | https://hmihotelgroup.com/crownpalais-kobe/ |
| ホテル ラ・スイート神戸ハーバーランド | https://www.l-s.jp/ |
| フォーポイント フレックス by シェラトン 神戸三宮 | https://www.marriott.com/ja/hotels/ukbxf-four-points-flex-kobe-sannomiya/overview/ |
その他の施設もございます。ご予約時に「検索結果画面」にてご確認ください。
満席・満室等の理由により「検索結果画面」にて施設および対象プランが表示されない場合があります。あらかじめご了承ください。
満席・満室等の理由により「検索結果画面」にて施設および対象プランが表示されない場合があります。あらかじめご了承ください。
広島県広島市クーポン利用可能施設(一例)
| シェラトングランドホテル広島 | https://www.marriott.com/ja/hotels/hijsi-sheraton-grand-hiroshima-hotel/overview/ |
|---|---|
| 三井ガーデンホテル広島 | http://www.gardenhotels.co.jp/hiroshima/ |
| ホテルグランヴィア広島 | http://www.hgh.co.jp/ |
| グランドプリンスホテル広島 | http://www.princehotels.co.jp/hiroshima/ |
| リーガロイヤルホテル広島 | http://www.rihga.co.jp/hiroshima/index.html |
| オリエンタルホテル広島 | https://oriental-hiroshima.com/ |
| 広島ワシントンホテル | http://washington-hotels.jp/hiroshima/ |
| ザ ロイヤルパークホテル広島リバーサイド | https://www.the-royalpark.jp/the/hiroshimars/ |
| ホテルインターゲート広島 | https://www.intergatehotels.jp/hiroshima/ |
| ヒルトン広島 | https://hiroshima.hiltonjapan.co.jp/ |
その他の施設もございます。ご予約時に「検索結果画面」にてご確認ください。
満席・満室等の理由により「検索結果画面」にて施設および対象プランが表示されない場合があります。あらかじめご了承ください。
満席・満室等の理由により「検索結果画面」にて施設および対象プランが表示されない場合があります。あらかじめご了承ください。
岩手県盛岡市クーポン利用可能施設(一例)
| ワシントンR&Bホテル盛岡駅前 | https://www.washingtonhotel.co.jp/rb/morioka/ |
|---|---|
| ダイワロイネットホテル盛岡 | http://www.daiwaroynet.jp/morioka/ |
| ホテルパールシティ盛岡 | https://hmihotelgroup.com/pearlcity-morioka/ |
| アートホテル盛岡 | http://art-morioka.com/ |
| ホテルメトロポリタン盛岡 | https://morioka.metropolitan.jp/ |
| つなぎ温泉 ホテル紫苑 | http://www.hotel-shion.com/ |
| 北ホテル | http://www.kitahotel.jp |
| フォーポイント フレックス by シェラトン 盛岡 | https://www.marriott.com/ja/hotels/hnamu-four-points-flex-morioka/overview/ |
| ダイワロイネットホテル盛岡駅前 | https://www.daiwaroynet.jp/morioka-ekimae/ |
| リッチモンドホテル盛岡駅前 | https://richmondhotel.jp/morioka/ |
その他の施設もございます。ご予約時に「検索結果画面」にてご確認ください。
満席・満室等の理由により「検索結果画面」にて施設および対象プランが表示されない場合があります。あらかじめご了承ください。
満席・満室等の理由により「検索結果画面」にて施設および対象プランが表示されない場合があります。あらかじめご了承ください。
北海道富良野市クーポン利用可能施設(一例)
| 新富良野プリンスホテル | http://www.princehotels.co.jp/newfurano/ |
|---|---|
| FURANO NATULUX HOTEL | http://www.natulux.com/ |
| リゾートイン ノースカントリー | http://www.north-country.co.jp/ |
| ホテルナトゥールヴァルト富良野 | http://naturwald-furano.com/ |
| ホテル・ベルヒルズ | http://www.bellhills.jp/ |
| 富良野リゾートホテル エーデルヴェルメ | http://www.edelwarme.jp/ |
| ホテルムニン富良野(Hotel Munin Furano) | https://www.hotelmunin.com/ |
| 天然温泉 紫雲の湯 ラビスタ富良野ヒルズ | https://www.hotespa.net/hotels/furano/ |
| ワイナリーホテル&コンドミニアム一花 | https://hotel-hitohana.com/ |
| Nozo Hotel | https://nozohotel.com/ |
その他の施設もございます。ご予約時に「検索結果画面」にてご確認ください。
満席・満室等の理由により「検索結果画面」にて施設および対象プランが表示されない場合があります。あらかじめご了承ください。
満席・満室等の理由により「検索結果画面」にて施設および対象プランが表示されない場合があります。あらかじめご了承ください。
北海道洞爺湖町クーポン利用可能施設(一例)
| 洞爺湖万世閣 ホテルレイクサイドテラス | https://www.toyamanseikaku.jp/ |
|---|---|
| 洞爺観光ホテル | http://www.toyakanko.com/ |
| 絶景の湯宿 洞爺湖畔亭 | http://www.toya-kohantei.com/ |
| ホテルグランドトーヤ | http://www.grandtoya.com |
| ゆとりろ洞爺湖 | https://yutorelo-toyako.com/ |
| ザ・ウィンザーホテル洞爺リゾート&スパ | http://www.windsor-hotels.co.jp/ |
| ザ レイクビュー TOYA 乃の風リゾート | http://nonokaze-resort.com/ |
| WE Hotel Toya | https://wehoteltoya.com |
| HOTEL COCOA RESORT | https://cocoaresort.jp/ |
その他の施設もございます。ご予約時に「検索結果画面」にてご確認ください。
満席・満室等の理由により「検索結果画面」にて施設および対象プランが表示されない場合があります。あらかじめご了承ください。
満席・満室等の理由により「検索結果画面」にて施設および対象プランが表示されない場合があります。あらかじめご了承ください。
千葉県浦安市クーポン利用可能施設(一例)
| ヒルトン東京ベイ | https://tokyobay.hiltonjapan.co.jp/ |
|---|---|
| オリエンタルホテル東京ベイ | http://www.oriental-hotel.co.jp/ |
| 東京ベイ舞浜ホテル | http://www.maihamahotel.jp/ |
| 東京ベイ舞浜ホテル ファーストリゾート | https://www.maihamahotel-firstresort.jp/ |
| シェラトン・グランデ・トーキョーベイ・ホテル | https://www.marriott.com/ja/hotels/tyosi-sheraton-grande-tokyo-bay-hotel/overview/ |
| ホテルオークラ東京ベイ | http://www.okuratokyobay.net/ |
| 三井ガーデンホテルプラナ東京ベイ | https://www.gardenhotels.co.jp/prana-tokyobay/ |
| 浦安ブライトンホテル東京ベイ | https://urayasu.brightonhotels.co.jp/index.html |
| ホテル エミオン 東京ベイ | http://www.hotel-emion.jp/ |
| グランドニッコー東京ベイ 舞浜 | https://tokyobay.grandnikko.com/ |
| 東京ディズニーランド(R)ホテル | https://www.tokyodisneyresort.jp/hotel/tdh.html |
| 東京ディズニーシー・ホテルミラコスタ(R) | https://www.tokyodisneyresort.jp/hotel/dhm.html |
| ディズニーアンバサダー(R)ホテル | https://www.tokyodisneyresort.jp/hotel/dah.html |
| 東京ディズニーセレブレーションホテル(R) | https://www.tokyodisneyresort.jp/hotel/dch.html |
| 東京ディズニーリゾート・トイ・ストーリーRホテル | https://www.tokyodisneyresort.jp/hotel/tsh.html |
| 東京ディズニーシー・ファンタジースプリングスホテル | https://www.tokyodisneyresort.jp/hotel/fsh.html |
その他の施設もございます。ご予約時に「検索結果画面」にてご確認ください。
満席・満室等の理由により「検索結果画面」にて施設および対象プランが表示されない場合があります。あらかじめご了承ください。
満席・満室等の理由により「検索結果画面」にて施設および対象プランが表示されない場合があります。あらかじめご了承ください。
福岡県福岡市クーポン利用可能施設(一例)
| ホテル日航福岡 | http://www.hotelnikko-fukuoka.com/ |
|---|---|
| 博多東急REIホテル | https://www.tokyuhotels.co.jp/hakata-r/ |
| ホテルモントレ ラ・スール福岡 | https://www.hotelmonterey.co.jp/lasoeur_fukuoka/ |
| 博多エクセルホテル東急 | https://www.tokyuhotels.co.jp/hakata-e/ |
| ソラリア西鉄ホテル福岡 | https://nnr-h.com/solaria/fukuoka/ |
| 西鉄グランドホテル | https://nnr-h.com/grandhotel/ |
| JR九州ホテル ブラッサム福岡 | https://www.jrk-hotels.co.jp/Fukuoka/ |
| ホテル モンテ エルマーナ福岡 | https://www.monte-hermana.jp/fukuoka/ |
| ホテルモントレ福岡 | https://www.hotelmonterey.co.jp/fukuoka/ |
| ホテルJALシティ福岡 天神 | https://www.fukuoka-tenjin.hoteljalcity.com/ |
その他の施設もございます。ご予約時に「検索結果画面」にてご確認ください。
満席・満室等の理由により「検索結果画面」にて施設および対象プランが表示されない場合があります。あらかじめご了承ください。
満席・満室等の理由により「検索結果画面」にて施設および対象プランが表示されない場合があります。あらかじめご了承ください。
京都府京丹後市クーポン利用可能施設(一例)
| 海花亭 花御前 | https://www.kaikatei.net/ |
|---|---|
| 蒲井温泉 いっぺん庵 | https://www.1-pen.net/ |
| 離れの宿 和楽 | https://www.waraku-yado.jp/ |
| リゾーピア久美浜 | https://www.rtg.jp/hotels/smc/kumi/ |
| KISSUIEN Stay&Food | https://kissuien.jp/ |
| 宇川温泉よし野の里 | https://ukawaonsen.jp |
| ホテル丹後王国 | https://www.hotel-tango-kingdom.com/ |
| 料理旅館夕日ヶ浦 | https://www.yuuhigaura.com/ |
| 碧翠御苑 | http://hekisui.jp/ |
| セントラーレ・ホテル京丹後 | https://www.centrale.co.jp/ |
その他の施設もございます。ご予約時に「検索結果画面」にてご確認ください。
満席・満室等の理由により「検索結果画面」にて施設および対象プランが表示されない場合があります。あらかじめご了承ください。
満席・満室等の理由により「検索結果画面」にて施設および対象プランが表示されない場合があります。あらかじめご了承ください。
神奈川県川崎市クーポン利用可能施設(一例)
| 川崎日航ホテル | https://www.kawasaki-nikko-hotel.com |
|---|---|
| 相鉄フレッサイン 川崎駅東口 | https://sotetsu-hotels.com/fresa-inn/kawasaki/ |
| リッチモンドホテルプレミア武蔵小杉 | http://richmondhotel.jp/musashikosugi/ |
| JR東日本ホテルメッツ 川崎(旧ホテルメッツ川崎) | http://www.hotelmets.jp/kawasaki/ |
| ダイワロイネットホテル川崎 | https://www.daiwaroynet.jp/kawasaki/ |
| JR東日本ホテルメッツ 溝ノ口(旧ホテルメッツ溝ノ口) | https://www.hotelmets.jp/mizonokuchi/ |
| 京急EXイン 京急川崎駅前 | https://www.keikyu-exinn.co.jp/hotel/kawasaki/ |
| 川崎キングスカイフロント 東急REIホテル | https://www.tokyuhotels.co.jp/kawasaki-r/ |
| ホテルメトロポリタン川崎 | https://kawasaki.metropolitan.jp/ |
| 天然温泉 扇浜の湯 ドーミーイン川崎 | https://www.hotespa.net/hotels/kawasaki/ |
その他の施設もございます。ご予約時に「検索結果画面」にてご確認ください。
満席・満室等の理由により「検索結果画面」にて施設および対象プランが表示されない場合があります。あらかじめご了承ください。
満席・満室等の理由により「検索結果画面」にて施設および対象プランが表示されない場合があります。あらかじめご了承ください。
返礼品詳細
-
提供元 田野屋紫蘭 配送 [常温] 配送注記 入金確認後、10日前後で発送いたします。
季節や天候により、お届けまでに通常よりお時間を頂戴する場合がございます。
特に冬季はお届けまでにお日にちを頂戴いたしますが、何卒ご了承ください。 -
内容量 「万能」 小粒 100g(100g×3個)
※パッケージサイズ:9cm×14.5cm×3.5cm
返礼品の感想
感想はまだありません。